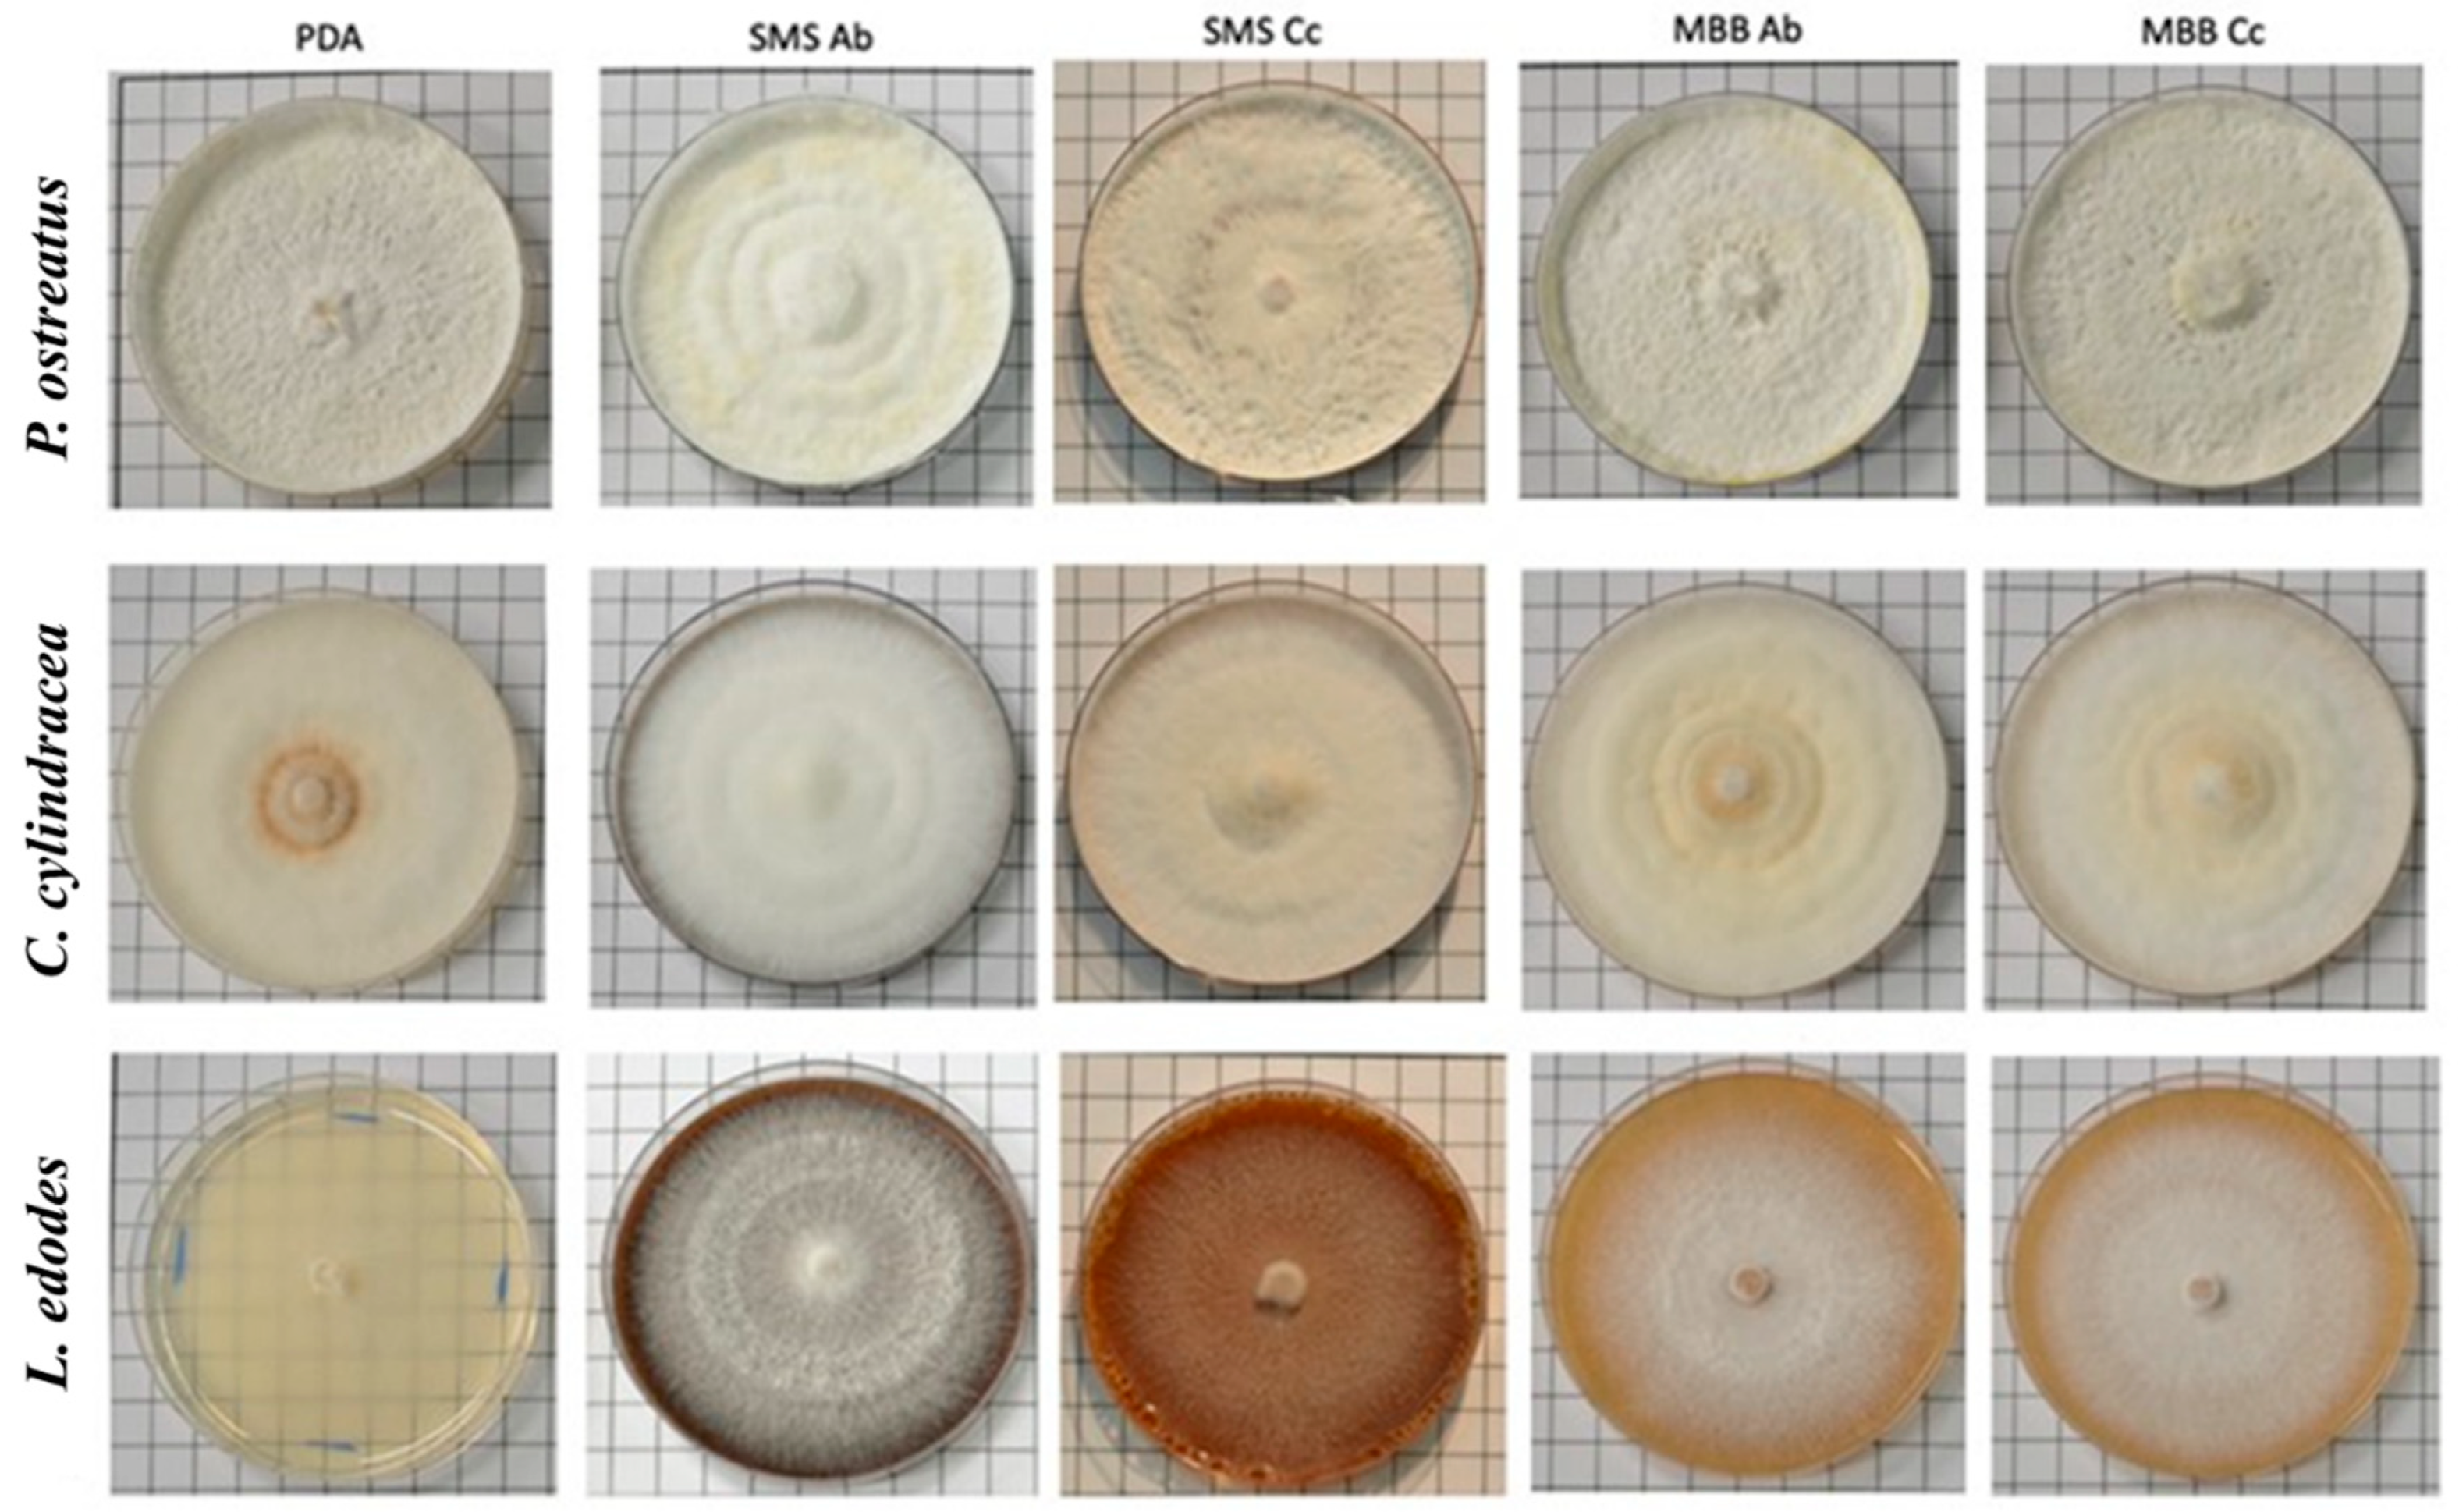
Foods 13 02789 g004

Mushroom By-Products as a Source of Growth Stimulation and Biochemical Composition Added-Value of Pleurotus ostreatus, Cyclocybe cylindracea, and Lentinula edodes
Abstract
1. Introduction
2. Materials and Methods
2.1. SMSs and MBBs
2.2. Active Filtrates Extraction
2.3. In Vitro Experiments
2.4. FT-IR Analyses of Mushrooms’ Mycelial Grown on SMSs and MBB Substrates
2.5. Data Analysis
3. Results
3.1. Mycelial Growth on SMSs and MBB Substrates
3.2. FT-IR Analysis on Mushrooms′ Biochemical Composition
4. Discussion
5. Conclusions
Supplementary Materials
Author Contributions
Funding
Institutional Review Board Statement
Informed Consent Statement
Data Availability Statement
Acknowledgments
Conflicts of Interest
References
- FAO. Moving Forward on Food Loss and Waste Reduction; Food and Agriculture Organization of the United Nations: Rome, Italy, 2019; Available online: https://www.fao.org/3/ca6030en/ca6030en.pdf (accessed on 1 November 2023).
- Kharola, S.; Ram, M.; Goyal, N.; Mangla, S.K.; Nautiyal, O.P.; Rawat, A.; Kazancoglu, Y.; Pant, D. Barriers to organic waste management in a circular economy. J. Clean. Prod. 2022, 362, 132282. [Google Scholar] [CrossRef]
- Abubakar, I.R.; Maniruzzaman, K.M.; Dano, U.L.; AlShihri, F.S.; AlShammari, M.S.; Ahmed, S.M.S.; Al-Gehlani, W.A.G.; Alrawaf, T.I. Environmental sustainability impacts of solid waste management practices in the global south. Int. J. Env. Res. Public Health 2022, 19, 12717. [Google Scholar] [CrossRef] [PubMed]
- Roy, S.; Barman, S.; Chakaraboty, U.; Chakraborty, B. Evaluation of spent mushroom substrate as biofertilizer for growth improvement of Capsicum annuum L. J. App. Biol. Biotech. 2015, 3, 22–27. [Google Scholar] [CrossRef]
- Niego, A.G.; Rapior, S.; Thongklang, N.; Raspé, O.; Jaidee, W.; Lumyong, S.; Hyde, K.D. Macrofungi as a nutraceutical source: Promising bioactive compounds and market value. J. Fungi 2021, 7, 397. [Google Scholar] [CrossRef]
- Atallah, E.; Zeaiter, J.; Ahmad, M.N.; Leahy, J.J.; Kwapinski, W. Hydrothermal carbonization of spent mushroom compost waste compared against torrefaction and pyrolysis. Fuel Process. Technol. 2021, 216, 106795. [Google Scholar] [CrossRef]
- Gao, X.; Tang, X.; Zhao, K.; Balan, V.; Zhu, Q. Biogas production from anaerobic co-digestion of spent mushroom substrate with different livestock manure. Energies 2021, 14, 570. [Google Scholar] [CrossRef]
- García-Delgado, C.; Jiménez-Ayuso, N.; Frutos, I.; Gárate, A.; Eymar, E. Cadmium and lead bioavailability and their effects on polycyclic aromatic hydrocarbons biodegradation by spent mushroom substrate. Environ. Sci. Pollut. Res. 2013, 20, 8690–8699. [Google Scholar] [CrossRef]
- Leong, Y.K.; Ma, T.W.; Chang, J.S.; Yang, F.C. Recent advances and future directions on the valorization of spent mushroom substrate (SMS): A review. Biores. Technol. 2022, 344, 126157. [Google Scholar] [CrossRef]
- Medina, E.; Paredes, C.; Bustamante, M.A.; Moral, R.; Moreno-Caselles, J. Relationships between soil physico-chemical, chemical and biological properties in a soil amended with spent mushroom substrate. Geoderma 2012, 173, 152–156. [Google Scholar] [CrossRef]
- Wang, S.; Xu, F.; Li, Z.; Zhao, S.; Song, S.; Rong, C.; Geng, X.; Liu, Y. The spent mushroom substrates of Hypsizigus marmoreus can be an effective component for growing the oyster mushroom Pleurotus ostreatus. Sci. Hort. 2015, 186, 217–222. [Google Scholar] [CrossRef]
- Sharma, D.D. Classifying buyers to gain marketing insight: A relationships approach to professional services. Int. Bus. Rev. 1994, 3, 15–30. [Google Scholar] [CrossRef]
- Kilpatrick, M.; Murray, D.J.; Ward, F. Influence of substrate formulation and autoclave treatment on Lentinula edodes production. In: Van Griensven, editor. Science and Cultivation of Edible Fungi. Balkema Publishers; Rotterdam: 2000. Mushroom Sci. 2000, 15, 803–810. [Google Scholar]
- Ahlawat, O.P.; Kaur, H. Re-use of Agaricus bisporus spent compost for commercial scale compost making of the succeeding crop of A. bisporus. Int. J.Curr. Microbiol. App. Sci. 2019, 8, 177–186. [Google Scholar] [CrossRef]
- Sobal, M.; Martínez-Carrera, D.; Morales, P.; Roussos, S. Classical characterization of mushroom genetic resources from temperate and tropical regions of Mexico. Micol. Apl. Int. 2007, 19, 15–23. [Google Scholar]
- RStudio, T. RStudio: Integrated Development for R; RStudio Inc.: Boston, MA, USA, 2020; Available online: http://www.rstudio.com/ (accessed on 1 November 2023).
- Baeva, E.; Bleha, R.; Sedliaková, M.; Sushytskyi, L.; Švec, I.; Copíková, J.; Jablonsky, I.; Kloucek, P.; Synytsya, A. Evaluation of the cultivated mushroom Pleurotus ostreatus basidiocarps using vibration spectroscopy and chemometrics. Appl. Sci. 2020, 10, 8156. [Google Scholar] [CrossRef]
- Boureghda, Y.; Satha, H.; Bendebane, F. Chitin–glucan complex from Pleurotus ostreatus mushroom: Physicochemical characterization and comparison of extraction methods. Waste Biomass Valoriz. 2021, 12, 6139–6153. [Google Scholar] [CrossRef]
- Meenu, M.; Xu, B. Application of vibrational spectroscopy for classification, authentication and quality analysis of mushroom: A concise review. Food Chem. 2019, 289, 545–557. [Google Scholar] [CrossRef]
- Mohacek-Grosev, V.; Bozac, R.; Puppels, G.J. Vibrational spectroscopic characterization of wild growing mushrooms and toadstools. Spectrochim. Acta 2001, 57, 2815–2829. [Google Scholar] [CrossRef]
- Synytsya, A.; Novak, M. Structural analysis of glucans. Ann. Translat. Med. 2014, 2, 17. [Google Scholar] [CrossRef]
- Correa, R.C.G.; Brugnari, T.; Bracht, A.; Peralta, R.M.; Ferreira, I.C.F.R. Biotechnological, nutritional and therapeutic uses of Pleurotus spp. (Oyster mushroom) related with its chemical composition: A review on the past decade findings. Trends Food Sci. Technol. 2016, 50, 103–117. [Google Scholar] [CrossRef]
- Lou, Z.; Sun, Y.; Bian, S.; Ali Baig, S.; Hu, B.; Xu, X. Nutrient conservation during spent mushroom compost application using spent mushroom substrate derived biochar. Chemosphere 2017, 169, 23–31. [Google Scholar] [CrossRef] [PubMed]
- Mohd Hanafi, F.H.; Rezania, S.; Mat Taib, S.; Md Din, M.F.; Yamauchi, M.; Sakamoto, M.; Hara, H.; Park, J.; Ebrahimi, S.S. Environmentally sustainable applications of agro-based spent mushroom substrate (SMS): An overview. J. Mater. Cycles Waste Manag. 2018, 20, 1383–1396. [Google Scholar] [CrossRef]
- Akdeniz, N.A. Systematic review of biochar use in animal waste composting. Waste Manag. 2019, 88, 291–300. [Google Scholar] [CrossRef] [PubMed]
- Carrasco-González, J.A.; Serna-Saldívar, S.O.; Gutiérrez-Uribe, J.A. Nutritional composition and nutraceutical properties of the Pleurotus fruiting bodies: Potential use as food ingredient. J. Food Compos. Anal. 2017, 58, 69–81. [Google Scholar] [CrossRef]
- Wu, J.; Kawagishi, H. Plant growth regulators from mushrooms. J. Antibiot. 2020, 73, 657–665. [Google Scholar] [CrossRef] [PubMed]
- Kim, H.; Kang, S.; Li, K.; Jung, D.; Park, K.; Lee, J. Preparation and characterization of various chitin-glucan complexes derived from white button mushroom using a deep eutectic solvent-based ecofriendly method. Int. J. Biol. Macromol. 2022, 169, 122–129. [Google Scholar] [CrossRef] [PubMed]
- Sandula, J.; Kogan, G.; Kacurakova, M.; Machova, E. Microbial (1-3)-β-d-glucans, their preparation, physico-chemical characterization and immunomodulatory activity. Carbohyd. Polym. 1999, 38, 247–253. [Google Scholar] [CrossRef]
- Pokhrel, C.P.; Yadav, R.K.P.; Ohga, S. Effects of physical factors and synthetic media on mycelial growth of Lyophyllum decastes. J. Ecobiotech. 2009, 1, 46–50. [Google Scholar]
- Noonsong, V. Recycling of spent Pleurotus compost for production of the Agrocybe cylindracea. Mycosphere 2016, 7, 36–43. [Google Scholar] [CrossRef]
- Braat, N.; Koster, M.C.; Wösten, H.A.B. Beneficial interactions between bacteria and edible mushrooms. Fungal Biol. Rev. 2022, 39, 60–72. [Google Scholar] [CrossRef]

| Mycelial Characteristics | ||||||
|---|---|---|---|---|---|---|
| Mushroom | Substrate | Texture | Density | Growth | Aerial Hyphae | Color |
| PDA | Cottony | ++ | Regular | Regular | White | |
| SMS Ab | Cottony | +++ | Regular | Abundant | Off-white | |
| P. ostreatus | SMS Cc | Floccose | ++ | Regular | Regular | White |
| MBB Ab | Cottony | ++ | Regular | Regular | White | |
| MBB Cc | Cottony | ++ | Regular | Regular | White | |
| PDA | Cottony | ++ | Regular | Regular | Off-white | |
| SMS Ab | Floccose | +++ | Regular | Abundant | White | |
| C. cylindracea | SMS Cc | Floccose | ++ | Regular | Abundant | Off-white |
| MBB Ab | Floccose | +++ | Regular | Abundant | Off-white | |
| MBB Cc | Floccose | +++ | Regular | Abundant | Off-white | |
| PDA | Cottony | + | Irregular | Scarce | White | |
| SMS Ab | Floccose | +++ | Irregular | Abundant | White | |
| L. edodes | SMS Cc | Cottony | + | Irregular | Scarce | Off-white |
| MBB Ab | Cottony | ++ | Irregular | Regular | White | |
| MBB Cc | Floccose | ++ | Irregular | Regular | White | |
Disclaimer/Publisher’s Note: The statements, opinions and data contained in all publications are solely those of the individual author(s) and contributor(s) and not of MDPI and/or the editor(s). MDPI and/or the editor(s) disclaim responsibility for any injury to people or property resulting from any ideas, methods, instructions or products referred to in the content. |
© 2024 by the authors. Licensee MDPI, Basel, Switzerland. This article is an open access article distributed under the terms and conditions of the Creative Commons Attribution (CC BY) license (https://creativecommons.org/licenses/by/4.0/).
Share and Cite
Carminati, G.; Di Foggia, M.; Garagozzo, L.; Di Francesco, A. Mushroom By-Products as a Source of Growth Stimulation and Biochemical Composition Added-Value of Pleurotus ostreatus, Cyclocybe cylindracea, and Lentinula edodes. Foods 2024, 13, 2789. https://doi.org/10.3390/foods13172789
Carminati G, Di Foggia M, Garagozzo L, Di Francesco A. Mushroom By-Products as a Source of Growth Stimulation and Biochemical Composition Added-Value of Pleurotus ostreatus, Cyclocybe cylindracea, and Lentinula edodes. Foods. 2024; 13(17):2789. https://doi.org/10.3390/foods13172789
Chicago/Turabian StyleCarminati, Gaia, Michele Di Foggia, Luca Garagozzo, and Alessandra Di Francesco. 2024. "Mushroom By-Products as a Source of Growth Stimulation and Biochemical Composition Added-Value of Pleurotus ostreatus, Cyclocybe cylindracea, and Lentinula edodes" Foods 13, no. 17: 2789. https://doi.org/10.3390/foods13172789
APA StyleCarminati, G., Di Foggia, M., Garagozzo, L., & Di Francesco, A. (2024). Mushroom By-Products as a Source of Growth Stimulation and Biochemical Composition Added-Value of Pleurotus ostreatus, Cyclocybe cylindracea, and Lentinula edodes. Foods, 13(17), 2789. https://doi.org/10.3390/foods13172789

